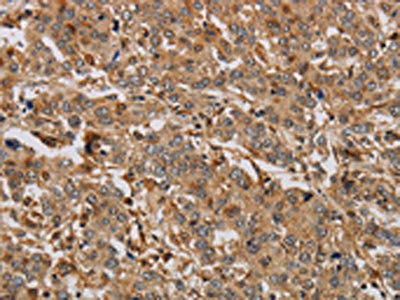

-
中文名稱:ACHE兔多克隆抗體
-
貨號:CSB-PA114463
-
規格:¥1100
-
圖片:
-
The image on the left is immunohistochemistry of paraffin-embedded Human liver cancer tissue using CSB-PA114463(ACHE Antibody) at dilution 1/20, on the right is treated with synthetic peptide. (Original magnification: ×200)
-
The image on the left is immunohistochemistry of paraffin-embedded Human colon cancer tissue using CSB-PA114463(ACHE Antibody) at dilution 1/20, on the right is treated with synthetic peptide. (Original magnification: ×200)
-
Gel: 8%SDS-PAGE, Lysate: 40 μg, Lane: Raji cells, Primary antibody: CSB-PA114463(ACHE Antibody) at dilution 1/250, Secondary antibody: Goat anti rabbit IgG at 1/8000 dilution, Exposure time: 2 minutes
-
-
其他:
產品詳情
-
Uniprot No.:
-
基因名:
-
別名:ACEE antibody; ACES_HUMAN antibody; Acetylcholinesterase antibody; AChE antibody; Apoptosis related acetylcholinesterase antibody; ARACHE antibody; N ACHE antibody; N-ACHE antibody; YT antibody; YT blood group antibody
-
宿主:Rabbit
-
反應種屬:Human,Mouse,Rat
-
免疫原:Synthetic peptide of Human ACHE
-
免疫原種屬:Homo sapiens (Human)
-
標記方式:Non-conjugated
-
抗體亞型:IgG
-
純化方式:Antigen affinity purification
-
濃度:It differs from different batches. Please contact us to confirm it.
-
保存緩沖液:-20°C, pH7.4 PBS, 0.05% NaN3, 40% Glycerol
-
產品提供形式:Liquid
-
應用范圍:ELISA,WB,IHC
-
推薦稀釋比:
Application Recommended Dilution ELISA 1:1000-1:2000 WB 1:200-1:1000 IHC 1:25-1:100 -
Protocols:
-
儲存條件:Upon receipt, store at -20°C or -80°C. Avoid repeated freeze.
-
貨期:Basically, we can dispatch the products out in 1-3 working days after receiving your orders. Delivery time maybe differs from different purchasing way or location, please kindly consult your local distributors for specific delivery time.
-
用途:For Research Use Only. Not for use in diagnostic or therapeutic procedures.
相關產品
靶點詳情
-
功能:Terminates signal transduction at the neuromuscular junction by rapid hydrolysis of the acetylcholine released into the synaptic cleft. Role in neuronal apoptosis.
-
基因功能參考文獻:
- 1-Naphthyl acetate (1-NA) to be a better alternative substrate for AChE than ATCh in terms of lower Km value. Its specificity appeared at least similar to ATCh. Therefore, we propose that 1-NA can be an attractive chromogenic substrate for the measurement of AChE activity. PMID: 30201403
- AChE polymorphism was significantly associated to reduced activity in both multiple sclerosis patients and controls. PMID: 29358722
- this study concludes and confirms that the aryl acylamidase activity of AChE is actively involved in the process of osteoblast differentiation and mineralization. PMID: 28852920
- The activity of human erythrocyte acetylcholinesterase differs in males and females and serves as a biomarker for diverse range of diseases. (Review) PMID: 28885588
- These findings suggest that, during Red Blood Cell ageing, GPI-linked proteins and integral membrane proteins are differentially sorted. Also, the vesicles that are generated in vitro show a fast and extensive loss of AChE activity, but not of AChE expression. PMID: 28518050
- Our analysis showed that DMSO is a considerably potent and highly selective irreversible mixed-competitive inhibitor of human AChE with IC50 values in the lower millimolar range, corresponding to 0.88% to 2.6% DMSO (v/v). Most importantly, 1-4% (v/v) DMSO, the commonly used experimental concentrations, showed approximately 37-80% inhibition of human AChE activity. PMID: 29017007
- This study found an increase in the protein and transcript levels of the non-cholinergic "readthrough" AChE (AChE-R) variants in Alzheimer's Disease patients compared to controls. PMID: 27258420
- The optimized docking protocol was validated by an external test set of 11 natural galantamine derivatives and the correlation coefficient between the docking scores and the pIC50 values was 0.800. The derived relationship was used to analyze the interactions between galantamine derivatives and AChE. PMID: 27490385
- These six-membered carbocycles showed nice inhibitory action against AChE and human carbonic anhydrase (hCA) II and I isoforms. The hCA I, II, and AChE were efficiently inhibited by these molecules, with Ki values in the range of 6.70-35.85 nM for hCA I, 18.77-60.84 nM for hCA II, and 0.74-4.60 for AChE, respectively PMID: 28613396
- Discovery of potent carbonic anhydrase, acetylcholinesterase, and butyrylcholinesterase enzymes inhibitors: The new amides and thiazolidine-4-ones synthesized on an acetophenone base.() PMID: 28544359
- hnRNP H binds to two specific G-runs in exon 5a of ACHE and activates the distal alternative 3 splice site (ss) between exons 5a and 5b. Furthermore, hnRNP H competes for binding of CstF64 to the overlapping binding sites in exon 5a, and suppresses the selection of a cryptic polyadenylation site, which additionally ensures transcription of the distal 3 ss required for the generation of AChET isoform. PMID: 28180311
- these results suggest that the design and investigation of multifunctional agents containing along with the acetylcholinesterase inhibitory segment also an antioxidant moiety capable of alleviating metal (copper)-induced oxidative stress, may be of importance in the treatment of Alzheimer's disease. PMID: 27230386
- Significance of AChE Genetic Variants to Risk of Toxicity from Cholinesterase Inhibitors (review) PMID: 27551784
- miR-124 could directly target the 3'-untranslated region of both signal transducer and activator of transcription 3 (STAT3) and acetylcholinesterase (AChE) mRNAs, and suppress their protein expressions. PMID: 27977009
- AChE activity in smokers was elevated (approx. 3% in males; 8% in females) relative to that in non-smokers. PMID: 28465191
- Unusually high AChE activity may be an effect marker of exposure to ethanol. The relationship between AChE and apoptosis might represent a novel mechanism of ethanol-associated neuronal injury. PMID: 28427893
- Thus C-547 is one of the most potent and selective reversible inhibitors of AChE with a long residence time, tau=20 min, longer than for other reversible inhibitors used in the treatment of myasthenia gravis. This makes C-547 a promising drug for the treatment of this disease PMID: 26929400
- Studies have demonstrated involvement of inherited tendencies of AChE increases in response to stress. PMID: 27138800
- Data suggest membranes of erythrocytes of patients with chronic obstructive pulmonary disease exhibit the following changes: increase in acetylcholinesterase; decrease in total ATPases and Na+/K+-ATPases; increase in lipid peroxidation/oxidative stress. PMID: 26369587
- These results suggest that the low AChE activity observed in larynx squamous cell carcinoma may be useful for predicting the outcome of patients. PMID: 26002584
- toxicogenetics/genetic association study in population in Turkey: Data suggest SNP in PON1 (192Q/R) is associated with susceptibility to organophosphate poisoning; plasma ACHE activities of exposed workers vary w/ PON1 genotype: 192RR>192QR>192QQ. PMID: 23625910
- Data suggest cholinesterase inhibitors with high potency have proper conformation in active site of ACHE and interact with key residues (Trp84, Phe330 at catalytic anionic site; Trp279 at peripheral anionic site; Gly118, Gly119, Ala201 at oxyanion hole. PMID: 26202430
- Phosphorylated p38, DNMT1 and AChE were aberrantly expressed in a subset of hepatocellular carcinoma tumors. PMID: 26299326
- Report acetylcholinesterase kinetics using fluorogenic probe for the investigation of free thiols. PMID: 26494253
- Report reactivation kinetics of a large series of bispyridinium oximes with organophosphate-inhibited human acetylcholinesterase. PMID: 26210933
- Case Report: repetitive obidoxime treatment induced increase of red blood cell acetylcholinesterase activity even in a late phase of a severe methamidophos poisoning. PMID: 26200596
- Low AChE activity in head and neck squamous cell carcinoma can be used to predict survival in patients with head and neck cancer. PMID: 25956553
- Data show that the 3D-quantitative structure property relationship (QSAR) models are capable of explaining the experimental phenomenon of ligand recognition and binding to acetylcholinesterase (AChE). PMID: 24905476
- The results suggest that interference with the enzymatic activities of AChE and/or interference with necroptosis may be novel approaches to influence ovarian functions. PMID: 25766324
- PRX-105 is a plant-derived recombinant version of the human 'read-through' acetylcholinesterase splice variant (AChE-R) which may be used for treatment/prevention of organophosphate poisoning. PMID: 26051873
- Data suggest that natural antisense RNA may play an important role in acetylcholinesterase (AChE) regulation via affecting the epigenetic modification in the AChE promoter region. PMID: 25240585
- QSAR analysis on tacrine-related acetylcholinesterase inhibitors. PMID: 25239202
- In symptomatic methylphosphonic difluoride poisoning high methylphosphonofluoridic acid concentrations in blood/tissues may lead to the formation of toxic phosphonyloximes after treatment with oximes. PMID: 25240274
- The results showed that AChE clusters colocalized with neurexin assemblies in the neurites of hippocampal neurons. PMID: 24594013
- Results suggest that AChE 7-20, a beta-hairpin region in AChE, might be a new motif in AChE capable of triggering Abeta aggregation and deposition PMID: 23981668
- Synaptic acetylcholinesterase may be a tumor suppressor and is modulated by miR-212 in non-small cell lung cancer. PMID: 23974008
- the T14 peptide derived from AChE produced a dose-dependent biphasic modulation of cortical networks activity dependent on the alpha-nAChR: study of a novel bioactive agent of high potential relevance to neurodegenerative disorders such as Alzheimer disease PMID: 23711548
- The mesenteric lymphatic vessels show many AChE positive nerve fibres around their wall with an almost plexiform distribution. PMID: 24402754
- The aim of this work is to review and discuss the recent findings about acetylcholinesterase, including its sensitivity to other pollutants and the expression of different splice variants. PMID: 23936791
- There is decreased expression of ACHE and CHRM3 in eccrine glands of cholinergic urticaria patients. PMID: 23748235
- AChE is regulated in two neuronal cell lines by APP in a manner independent of the generation of sAPPalpha, sAPPbeta, and AICD. PMID: 23897820
- Low AChE activity was associated with deficits in neurodevelopment, particularly in attention, inhibition, and memory in boys but not in girls. PMID: 24249815
- Data indicate that high AChE affinity of the compounds was achieved by optimizing different substituents on the pyridazinone ring, without sacrificing the AChE/BuChE selectivity profile. PMID: 23466605
- verify amplification and/or deletion in the ACHE, BCHE, EPHB4 and MME genes in 32 samples of sporadic breast cancer PMID: 23063927
- assayed the relative activities of AChE and BChE in membrane fractions and culture medium of three different neuronal cell lines, namely the neuroblastoma cell lines SH-SY5Y and NB7 and the basal forebrain cell line SN56 PMID: 23047022
- AChE contains a deep active site gorge with two sites of ligand binding, an acylation site (or A-site) containing the catalytic triad at the base of the gorge and a peripheral site (or P-site) near the gorge entrance. PMID: 23047027
- Free energy landscape for the binding process of Huperzine A to acetylcholinesterase PMID: 23440190
- Acetylcholinesterase inhibitor huperazine A improved, or partly reversed, the Abeta-induced damage of neurite outgrowth. PMID: 23119107
- AChE and BChE activities were decreased in prostate cancer patients PMID: 22560633
- results suggest that the glycosylation may affect AChE(H) enzymatic activity and trafficking, but not dimer formation. The present findings indicate the significance of N-glycosylation in controlling the biosynthesis of the AChE(H) dimer form PMID: 22805525
顯示更多
收起更多
-
亞細胞定位:Cell junction, synapse. Secreted. Cell membrane; Peripheral membrane protein.; [Isoform T]: Nucleus. Note=Only observed in apoptotic nuclei.; [Isoform H]: Cell membrane; Lipid-anchor, GPI-anchor; Extracellular side.
-
蛋白家族:Type-B carboxylesterase/lipase family
-
組織特異性:Isoform H is highly expressed in erythrocytes.
-
數據庫鏈接:
Most popular with customers
-
-
YWHAB Recombinant Monoclonal Antibody
Applications: ELISA, WB, IHC, IF, FC
Species Reactivity: Human, Mouse, Rat
-
Phospho-YAP1 (S127) Recombinant Monoclonal Antibody
Applications: ELISA, WB, IHC
Species Reactivity: Human
-
-
-
-
-